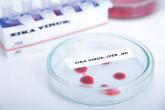

News

EZH2 inhibitors could improve treatment of CML, studies suggest
Image by Difu Wu Two preclinical studies published in Cancer Discovery suggest that EZH2 inhibitors might enhance the efficacy of treatment with...

Image by Difu Wu Two preclinical studies published in Cancer Discovery suggest that EZH2 inhibitors might enhance the efficacy of treatment with...

Photo by Daniel Sone HEIDELBERG, GERMANY—Scientists have developed a smartphone application called HemaApp that can be used to measure hemoglobin...

Photo by Nina Matthews A new study suggests that treating pregnant women according to the results of malaria tests does not lower the risk of...

The investigators note that this study “provides high-quality evidence that the combination of exenatide and dapagliflozin is more effective than...
A new study from Brazil demonstrates that microcephaly is strongly associated with congenital Zika virus infections, offering case-control...

Minimal residual disease negativity following treatment for newly diagnosed multiple myeloma is associated with long-term survival, according to...

There were 60 more pregnant women in the 50 states and the District of Columbia with laboratory evidence of Zika infection for the week ending...

Key clinical point:People with frequently painful knees often develop pain in joints outside the knee, and the sites vary from person to person....
LONDON—In patients with multiple sclerosis (MS), telerehabilitation is a convenient and practical method of performing physical...
LONDON—As has been previously shown with brain atrophy and lesion volume, retinal measures can have predictive value for medium-...